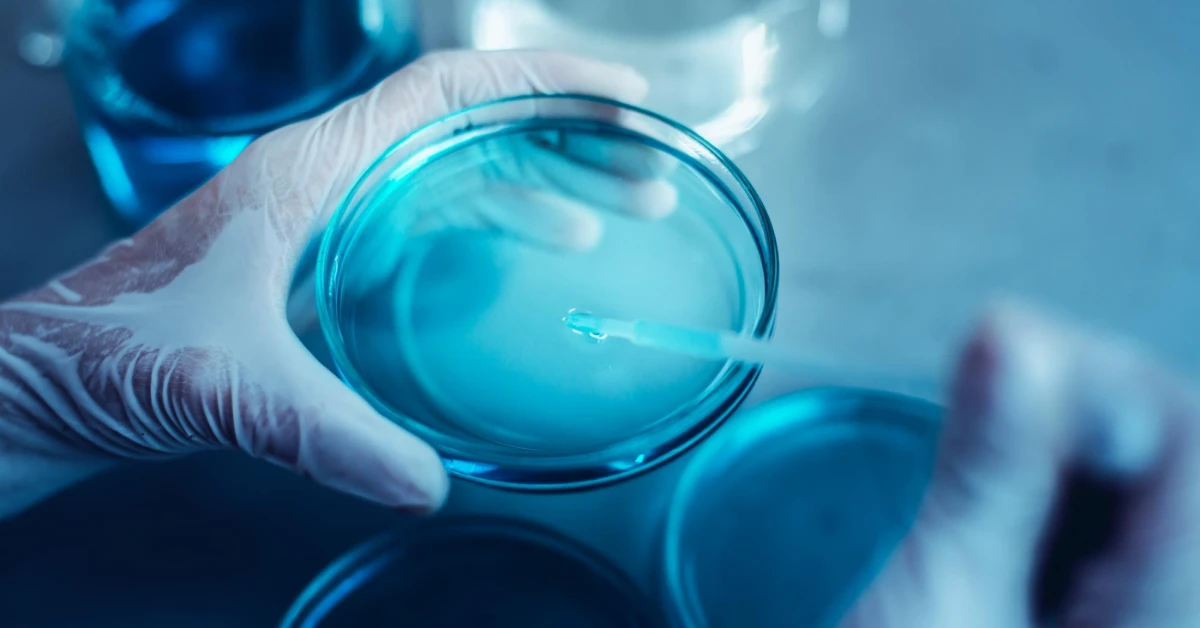
IVM

Safety Rate
IVM – In Vitro Maturation is a fertility treatment where immature eggs are collected from the ovaries and matured in the laboratory before being fertilized. Unlike IVF, which requires high doses of hormonal injections to mature eggs inside the ovaries, IVM allows eggs to develop externally reducing medical stress and overall treatment cost. During IVM Treatment in Chennai, doctors collect partially developed eggs, mature them under precise laboratory conditions, and then fertilize them with sperm. The resulting embryos are later transferred into the uterus, similar to IVF. This technique is particularly beneficial for women with Polycystic Ovary Syndrome (PCOS), hormone sensitivity, or those who wish to avoid ovarian hyperstimulation.
Choosing IVM Treatment in Chennai means opting for a fertility procedure that blends science, comfort, and affordability. Here’s why more couples are turning to this innovative treatment:
Clinics offering IVM Treatment in Chennai focus on patient-centered protocols that prioritize safety, comfort, and success. The process is tailored to each individual’s reproductive health, making it an inclusive option for many aspiring parents.
Here’s how IVM – In Vitro Maturation works in leading fertility centers across Chennai:
Initial Consultation and Assessment
A detailed fertility evaluation is done through hormone analysis, ultrasound, and medical history review. Specialists determine whether the patient is a suitable candidate for IVM Treatment in Chennai.
The entire process of IVM Treatment in Chennai is faster, more comfortable, and less taxing than conventional IVF, while maintaining promising success rates.
While both IVM and IVF aim to achieve pregnancy through assisted reproduction, there are key differences:
| Aspect | IVM – In Vitro Maturation | IVF (In Vitro Fertilization) |
|---|---|---|
| Egg Collection | Immature eggs retrieved | Mature eggs retrieved |
| Hormonal Stimulation | Minimal or no hormones | Requires high-dose hormone injections |
| Treatment Time | Shorter cycle | Longer cycle |
| Ideal For | PCOS, hormone sensitivity | Broader infertility conditions |
| Cost | Lower | Higher |
| Risk of OHSS | Very low | Moderate to high |
Couples choosing IVM Treatment in Chennai appreciate the lower medical burden and faster recovery, making it a comfortable and smart alternative to IVF.
With consistent innovation, clinics offering IVM Treatment in Chennai now achieve success rates close to IVF, making it a viable choice for many families.
The IVM Treatment in Chennai generally costs between ₹60,000 and ₹1,20,000 per cycle, depending on the clinic, lab facilities, and medication requirements. Compared to traditional IVF, IVM offers cost savings while maintaining comparable results. Many fertility centers in Chennai also provide flexible EMI plans and package options for couples seeking affordable fertility care.
The success of IVM – In Vitro Maturation depends on factors like age, egg quality, and overall reproductive health. Women under 35 years old often experience success rates between 35–45% per cycle, similar to certain IVF protocols. Clinics providing IVM Treatment in Chennai use advanced laboratory incubators and real-time embryo monitoring systems to improve fertilization outcomes. Combined with proper patient selection, emotional support, and holistic wellness programs, IVM continues to deliver excellent results with minimal physical stress.
You should consider consulting a fertility expert about IVM Treatment in Chennai if you:
Fertility centers offering IVM Treatment in Chennai conduct in-depth consultations, ensuring every patient receives the right guidance, education, and care before starting treatment.
IVM – In Vitro Maturation represents the future of gentle fertility care safe, efficient, and affordable. With minimal hormones, reduced stress, and quicker recovery, it’s the perfect option for those seeking a natural yet advanced fertility journey. By choosing IVM Treatment in Chennai, couples gain access to expert fertility specialists, cutting-edge labs, and compassionate care — transforming the path to parenthood into a stress-free and empowering experience.
Meet our experienced team of anaesthesiologists dedicated to your safety and comfort

Director

SENIOR EMBRYOLOGIST

JUNIOR EMBRYOLOGIST

FERTILITY COUNSELLOR
Yes, IVM Treatment in Chennai is safe and widely practiced for women with PCOS or those who wish to avoid hormonal overload. It’s less invasive and medically supervised throughout.
The entire process takes around 2–3 weeks, including consultation, egg retrieval, and embryo transfer shorter than a typical IVF cycle.
Success rates range from 30–45%, depending on age, health, and clinic expertise. Centers offering IVM Treatment in Chennai often match IVF success rates for eligible candidates.
Take the first step toward parenthood. Book an appointment with our expert team to receive expert guidance, emotional support, and advanced fertility solutions designed just for you.